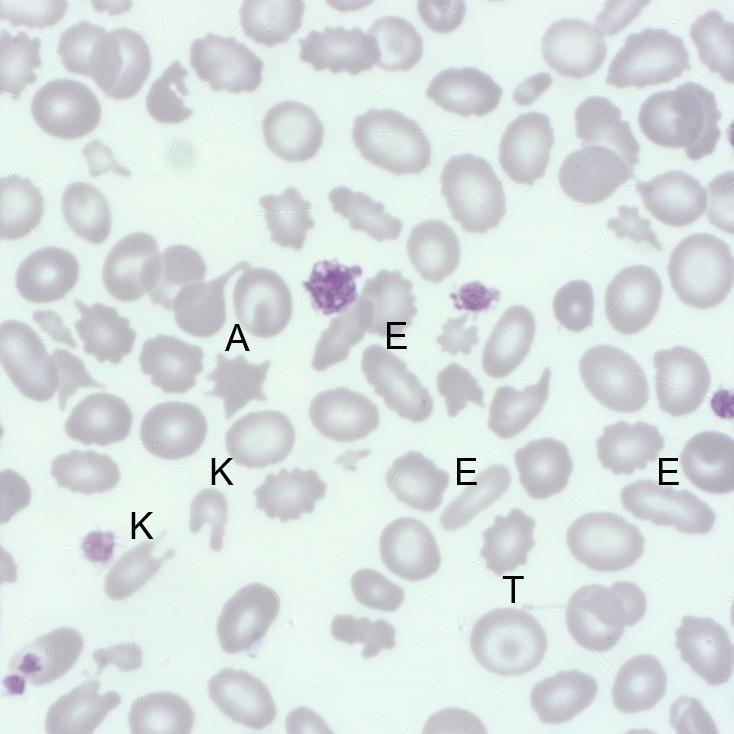
Figure A
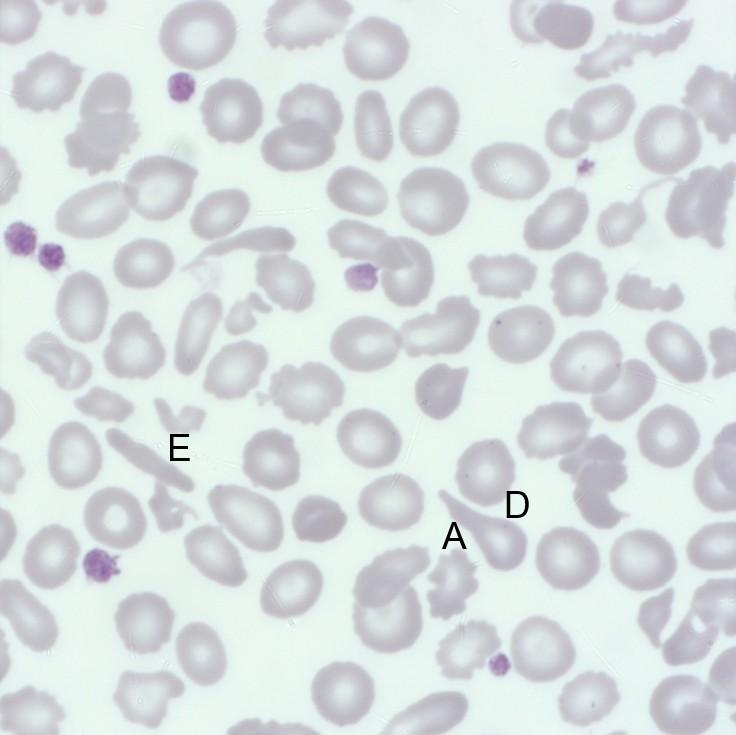
Figure B
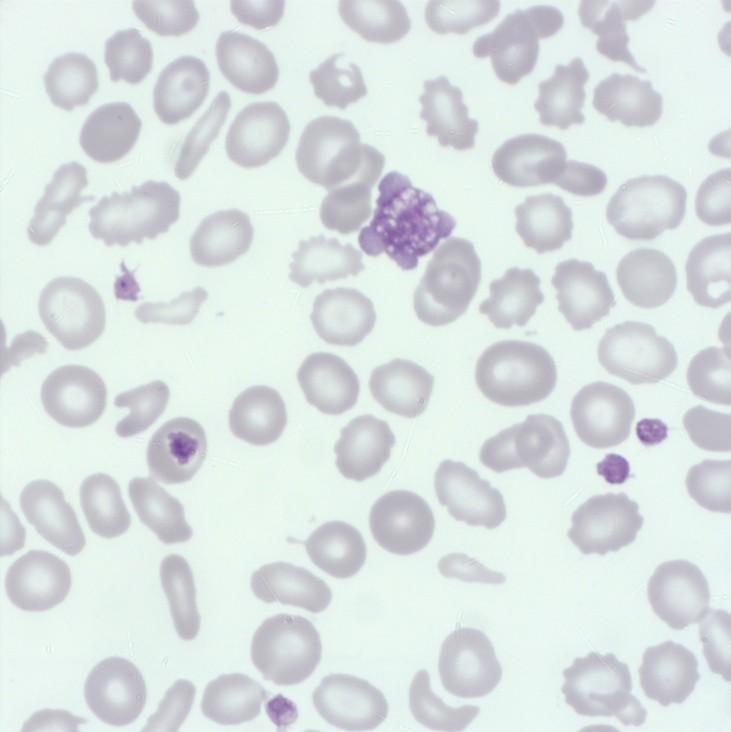
Figure C
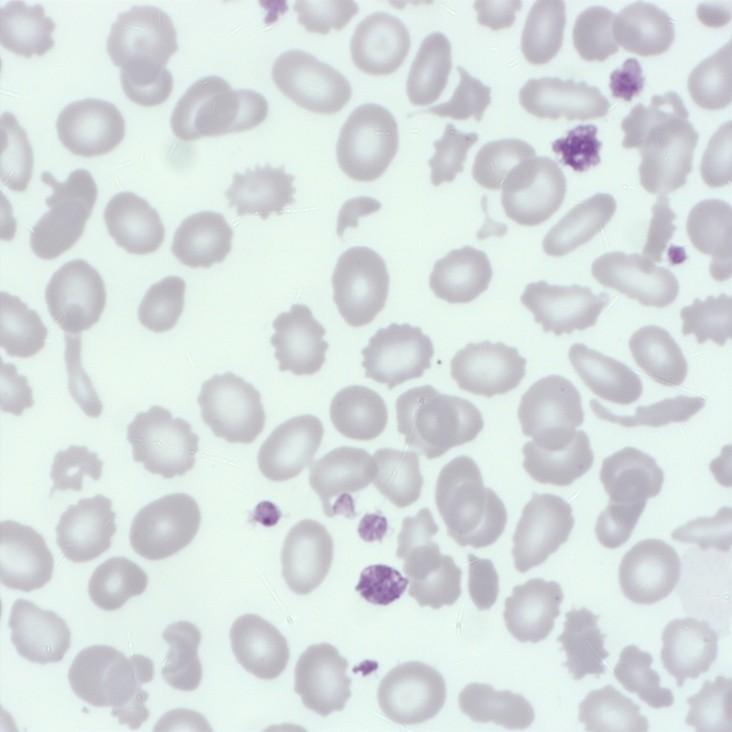
Figure D
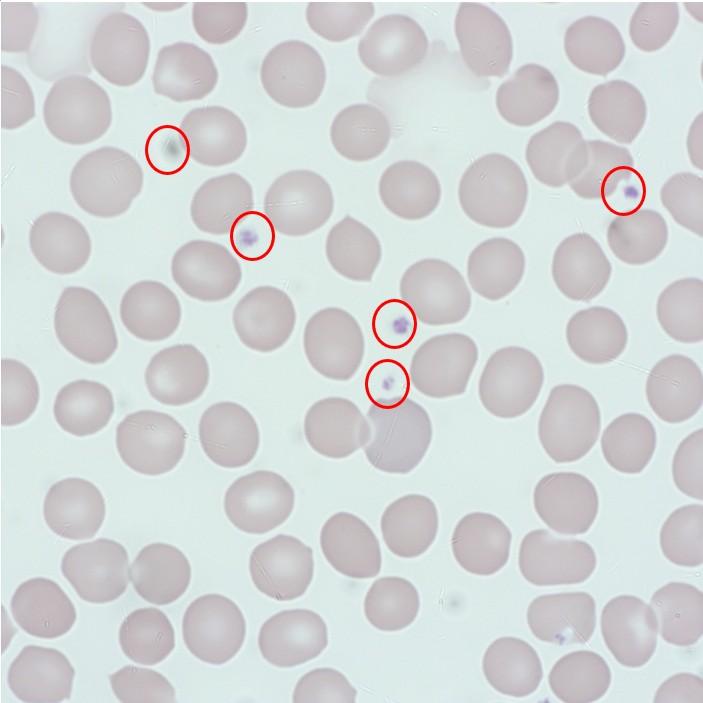
Platelets_1
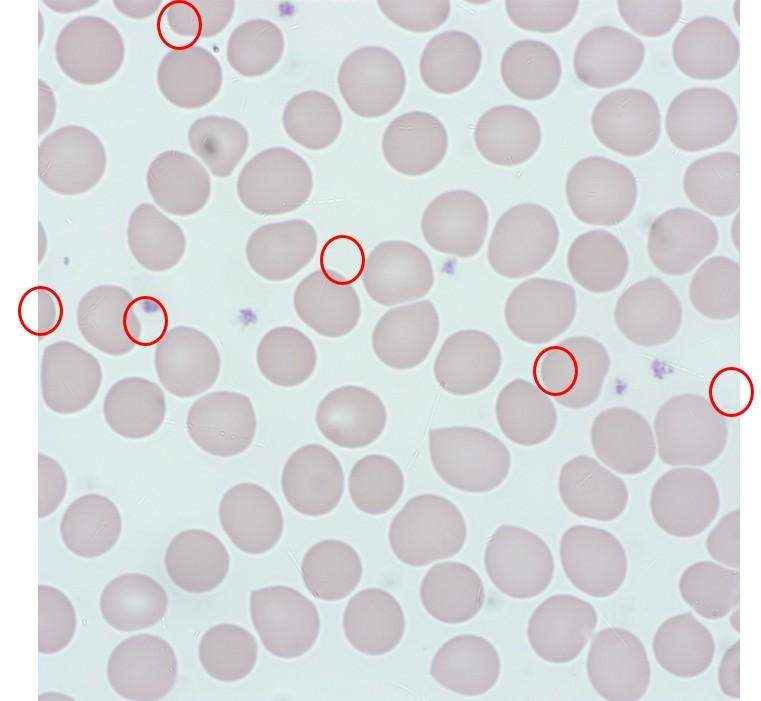
Platelets_2

Subscribe now!

Subscribe and receive Heme Insights from the next issue.
Female aged 61 known Beta Thalassemia
| FBC | |
|---|---|
| WBC 13.2 x 106/L | MCHC 30.7 (g/dL) |
| RBC 7.3 x 1012/L | PLT 493 x 106/L |
| HGB 126 (g/dL) | RDW-SD 45.4 (fL) |
| HCT 30.5 (%) | RDW-CV 25.3 (%) |
| MCV 55.9 (fL) | RBC and Platelets flagged on analyzer |
| MCH 17.1 (pg) | |
Microcytosis (+++).
Aniso-poikilocytosis (++) with presence of red blood cell fragments (visible "on the RBCs wall"), consistent with the RBC/PLT flag on the analyzer). Elliptocytes/Acanthocytes/Dacryocytes (++).
Target red cells (+).
Platelet anisocytosis with presence of giant platelets and very large platelet clusters at the edges of the smear: DO NOT REPORT the platelet result. Add a comment such as "underestimation of platelet count: PLT clumps." Thrombocytosis with the presence of giant platelets to be compared with the clinical context.
As can be seen from the examples (Figures A and B), there is a very large degree of difference in red cell size (Anisocytosis) and shape (Poikolocytosis).
Elliptocytes are the pencil-shaped red cells (E).
Figure A
Figure B
Acanthocytes (A) are red cells which have between 2 and 20 irregular spikes that are of unequal length and irregularly distributed over the surface of the cell.
Keratocytes (K) or horned cells – red cells with pairs of spikes are also visible and may be an indication of mechanically damaged red cells.
Dacrocytes (D) or teardrop cells can be visible and are an indicator of conditions such as bone marrow fibrosis, severe dyserythropoiesis, and also in certain hemolytic anemias.
Target cells (T) are also obvious.
Platelet anisocytosis describes that there is an increase in the size difference in the platelet population. In normal blood smears, the platelet size is generally consistent.
A comment was made regarding the presence of giant platelets, overall the platelet population appears to show that the majority of platelets are larger than in a normal blood smear, although not available one would suspect that the Mean Platelet Volume (MPV) would be increased.
Platelet anisocytosis can be seen in both the pictures below with a giant platelet (GP) identified in Figure C with Large Platelets (LP) identified in Figure D.
Figure C
Figure D
Figure E
In the picture (Figure E) above, we can see a large clump of platelets. Some of the platelets appear to have discharged the contents of their granules hence the grayish color. There doesn’t appear to be any signs of fibrin strands. Platelet clumping may be seen throughout the blood smear or just at the edges or the tail of the blood smear. Platelet clumping may indicate that the automated platelet is an underestimate of the actual platelet count. Platelet clumping may be induced by the presence of the EDTA therefore additional samples should be requested but using Sodium Citrate as the anticoagulant.
Platelets or thrombocytes are small (diameter 2 - 5 µm, volume 7 - 12 fL) anucleate discoid-shaped cells, they are the second most abundant cell type in the blood (normal range 150 – 450 x 109/L), they have a short span of between 7 - 10 days. Incredibly approximately 100 billion platelets need to be produced every day to maintain normal levels. Under the microscope, they appear as small unassuming gray cells with no obvious structure visible.
Platelets indicated by red circles
Megakaryocyte
Platelets are produced in the bone marrow and also possibly the lungs from Megakaryocytes which are very large (45 - 100 µm) nucleated cells as shown above. Platelet production is still not fully understood but the best-described mechanism is that megakaryocytes develop long cytoplasmic extensions called proplatelets, overlapping microtubules cause the proplatelet to extend. The proplatelet contains a string of platelets which break off from the proplatelet to become circulating platelets. Thrombopoietin is the major physiological regulator of platelet production. Proplatelets may occasionally be seen in blood smears as uniform, elongated tubular structures that have periodic platelet-sized swellings along the length and can be an indicator of increased platelet production. Newly formed platelets often referred to as reticulated platelets, young platelets, or immature platelets are defined as RNA-enriched and have long been thought to be hyper-reactive.
Platelets appear as unassuming cells but are packed full of important molecules stored within their granules. Platelets contain 3 types of granules alpha granules containing chemokines, platelet-derived growth factor receptors, fibrinogen, vWF, fibronectin, dense granules containing calcium ADT/ATP and lysosomal granules containing cathepsin, collagenase, elastase. In response to vessel injury platelets activate and rapidly undergo massive shape and ultrastructure changes, plasma membrane is altered with cytoplasmic projections emerging causing the platelet to take an “amoeboid form”. At the same time, platelets undergo granule centralization and discharge.
Platelets are essential in primary hemostasis and rapidly form a loose platelet plug to stop blood loss at the site of blood vessel injury. Exposure of the subendothelial tissue causes the adhesion of platelets to the damage due to the lack of production of platelet function inhibitors. Platelet activation then occurs causing the platelets to release potent activation factors such as ADP which leads to further recruitment and activation of platelets. Activated platelets bind fibrinogen which acts as a bridge between platelets causing platelet aggregation. Exposure of tissue endothelium initiates the plasma coagulation cascade which together with the aggregated platelets forms a firm clot.
Platelets also play an important role in combating infections. Platelets are able to act as primary immune cells, particularly in the context of sepsis and bacterial infections. Platelets quickly respond to infections by recognizing pathogens and releasing cytokines, chemokines, and growth factors that help attract and activate neutrophils and monocytes to the site of infection. Platelet-derived antimicrobial peptides (AMPs) are released by activated platelets which are able to disrupt bacterial membranes, leading to cell death. Platelets are able to interact with bacteria with some studies suggesting that platelets can segregate bacteria in the bloodstream, preventing them from spreading throughout the body.
The act of platelet aggregation also assists in the fight against infection by creating a physical barrier preventing bacteria from entering the bloodstream, as the fibrin matrix develops. Migrating immune cells are able to use the matrix, e.g., neutrophils and macrophages are able to use the matrix as a form of scaffolding to enhance their functionality.
Platelet-derived growth factors (PDGF) secreted by platelets at the site of injury may play an important role in the initiation of the wound repair process. The use of PDGF in the form of autologous platelet-rich plasma (PRP) can be used in numerous orthopedic and cosmetic therapies e.g., osteoarthritis, ligament injuries, cartilage injuries, plantar fasciitis, tendinopathies, and hair loss.
Looking down the microscope at those little gray shapes, it is hard to imagine just how important they are in the fight against blood loss and infection.
See these 3 Levey - Jenning (L-J) plots from a FBC analyzer. The range is +- 3SD (red lines).
Which one shows a positive bias?
The Answer: Plot C
Levey-Jenning (LJ) plots are a good way of visualizing the performance of any Quality Control (QC) result. Generally, they represent the number of Standard Deviation each result is away from the Target value. Plot C shows that the results are always above the target, and therefore, we can say that the parameter is showing a positive bias. The plot also shows that there is some variation in result which could be due to an analyzer performance issue. Plot A shows a near perfect performance.
Bibliography
Unveiling the Lifesavers: How Platelets Combat Sepsis and Bacterial Infections (How Platelets Combat Sepsis and Bacterial Infections)
Platelet Physiology and Biochemistry: A Topic as Relevant as Ever (Semin Thromb Hemost 2024; 50(05): 804-805)
Editorial Team
Kelly Duffy, Andrew Fisher, HORIBA UK Limited